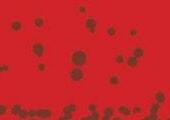
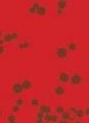

ToencoronauitbrakgebruikteBenvanOoijen(directeur vanDeTuinenvanAppeltern)zijnFacebookpaginaals dagboekendeeldezijnwekelijkservaringenen overwegingenmeteensteedsgroterwordende lezersgroep.Coronaheeftveelveranderdendoetdatnog steeds.Zijnkijkalsondernemer,vader,dorpsgenooten tuinmanopalleswatgebeurt,wordtzonderbedenkingen, maaraltijdpositiefeindigendweergegeven.Benprikkelt, analyseertenontroertdoorzijnopenen puremaniervan schrijven.Hijverhaaltoverzijnwerk,zijnmedewerkers,zijn gezin,zijnbijzondereontmoetingenendegebeurtenissen inwereldenzijndorp.





LezersherkennenzichinBen'sverhalen.Zegevenjehetgevoel nooitalleentestaan.Honderdverhalendietroostenenergiegeven omdewereldaantekunnenennogmooiertemaken. Datmaakt‘Omtedelen’eenprachtig geschenkomtedelen.
'Omtedelen'istebestellenvia www.appeltern.nl/shopofscandeQR-code

































Winter betekent sfeervol genieten in het Land van Maas & Waal. In december is er veel vertier op de ijsbanen, stijlvolle etalages voor shopplezier en tijd voor een gezellige lunch, borrel of diner. Samen genieten thuis, maar zeker ook in de musea, kastelen en natuur. Ontdek heerlijke horeca, mooie hotels en bed and breakfast’s & ga genieten van pure welness voor jezelf. Het Land van Maas & Waal is zeker UIT gaan met hoofdletters. Intieme theaters met leuke arrangementen en speciale programma’s nodigen jou uit.
Ook in januari is er veel te beleven. Voordeelshoppen, maar je wordt snel verleid met mooie nieuwe collecties. Het voorjaar begint te lonken. In februari zijn de carnavals kriebels voelbaar. Bezoek een kleurrijke carnavalsoptocht in de regio in het weekend van 18 en 19 februari. Altijd gezellig om samen met inwoners LEUT te hebben. Deze winter beleef jij samen met familie, vrienden of collega’s het Land daar achter die mooie heuvels.
Gastvrij, gevarieerd en uitdagend voor jong en oud.
Uitgever:
Hoofdredactie: Yvonne van der Bend (hoofdredacteur) yvonne@businessmedia4all.nl







Redactie: Chantal Fransen, Loet van Bergen, Joep Peters
Redactieadres: Tituslaan 13, 6642 AP Beuningen Tel. 024 67 76 930 Email. info@businessmedia4all.nl www.businessmedia4all.nl


Fotografie: Henk van der Bend
Vormgeving/opmaak: Esther Peters
Realisatie Druk & Productiebegeleiding Print Rendement, Henk van der Bend, Beuningen
Buitengewoon LVMW
Lifestyle & Wonen Uniek wonen Het verhaal LVMW SHOP and Enjoy Fashion Favorites Beauty en Vitaal Culinair Genieten Kriskras op de schaats Bijzonder overnachten Ondek de streek Business LVMW I LOVE LVMW
#LandvanMaasenWaalBuitengewoon
info@businessmedia4all.nl.

Verspreiding: • De uitgave is gratis verkrijgbaar in de gemeente Beuningen, Druten, West Maas en Waal en Wijchen en omstreken op ruim 400 uitgiftepunten.
• De uitgave is digitaal te lezen via www.businessmedia4all.nl en via het instagram en facebook account

Oplage: 10.000 exemplaren
Copyright: ©2022 Overname van artikelen/foto’s is slechts mogelijk na verkregen schriftelijke toestemming van de uitgever
Land van Maas & Waal Buitengewoon is een uitgave van Businessmedia….4all

MORE LVMW



Het Land van Maas & Waal kent drie theaters, waar je dichtbij geniet van mooie voorstellingen.
Het Agora Theater in Druten biedt jou deze winter een gevarieerd programma. Voor jong en oud is er een voorstelling . Een kleine greep uit het diverse aanbod tot 1 april 2023.
* Katiuscia Principato “Ziza wil geen Ninja zijn” - Over worden wat je wil, en over níet worden wat je niet wil!
* Marlijn Weerdenburg “ Mijn buik vol van de liefde” - Samen met haar band zingt Marlijn de longen uit haar lijf, maakt ze pijn bespreekbaar, maar deelt ze ook haar dankbaarheid voor het leven. Rauw en met de billen bloot, een voorstelling die gaat over de essentie van het leven.
* Sven Ratzke “Venus & Mars” - Sven Ratzke, entertainer pur sang en een internationale sensatie, bracht publiek en pers de laatste jaren al in vervoering met zijn Bowie-shows. Met zijn nieuwe show duikt hij in zijn catalogus van de mooiste songs van de afgelopen eeuw. Bezoek www.agoratheater.nl/programma


biedt een groot aanbod aan voorstellingen, die je ook kunt combineren met heerlijke borrelhapjes arrangementen Van Sparkling Christmas tot verteltheater met Abdelkader Benali “Moeder en zoon - Te gast in de keuken van Benali”. Een bezoek aan Mozaiek maakt UIT tot een 100% beleving. Bezoek www.mozaiekwijchen.nl
biedt jou een hele speciale podiumervaring. Je zit bijna op het toneel en dat is optimaal genieten. Bezoek deze winter familie, muziek en cabaretvoorstellingen zoals op 24 januari “Kom je Spelen” door Beeldmakerij Laros & De Jong en/of 28 januari “Best of 20 Years” met Stenzel en Kivits of op 26 maart “Vive La Chanson”met Britt Maria & Maurits Fondse. Bezoek
www.theaterdemolen.nl

Bezoek deze winter een levend monument uit het stoomtijdperk.
Bij Stoomgemaal de Tuut waan je je even in de jaren ’20 van de vorige eeuw. Het is een volledig gerestaureerd, werkend gemaal, en een testament van de eeuwige strijd tegen het water. Tijdens een bezoek leer je over de geschiedenis van watermanagement, en ontdek je wat het gemaal betekende voor de inwoners van het Land van Maas en Waal.
Tijdens de stoomweekeinden kun je het stoomgemaal van dichtbij in volle werking zien, maar een bezoek tijdens onze reguliere
Nu te zien van 20 november 2022 t/m 8 januari 2023 Wijvenwereld
In samenwerking met Het Gebroeders van Lymborch Huis presenteert Museum Kasteel Wijchen de tentoonstelling Wijvenwereld Een verrassende kijk op vrouwen in de late middeleeuwen. Een tentoonstelling over de positie van de vrouw in de 15de eeuw, zowel arm als rijk.
openingstijden is ook zeer de moeite waard: je mag het hele gemaal van binnen en buiten bekijken en met behulp van beeld, geluid en geur, prikkelen we je zintuigen. Zo nemen we je graag even mee naar vervlogen tijden.
Stoomgemaal de Tuut is een technisch, maar ook een sociaal maatschappelijk doorkijkje naar het begin van de twintigste eeuw. Je leert dus niet alleen de machines, maar ook de mensen kennen.

Een bezoek aan Stoomgemaal de Tuut past bij elk dagje uit. Als tussenstop of als eindbestemming, bij goed én bij slecht weer en natuurlijk met een lekker hapje of drankje na, in het gezellige café.
www.stoomgemaaldetuut.nl
Openingstijden November – April: Dinsdag t/m vrijdag – 11.00 tot 16.00 uur
In de tentoonstelling Wijvenwereld is gedurende 7 weken een heel bijzonder object te bewonderen: het Van BronckhorstBatenburg Getijdenboek. Het boek, in particulier bezit, is slechts 1 keer eerder tentoongesteld. Kasteel Wijchen was in de middeleeuwen in bezit van de familie Van Bronckhorst-Batenburg. Het bijzondere getijdenboek komt dus ‘thuis’: terug in de regio waar het boek ook daadwerkelijk is

gebruikt. Museum Kasteel Wijchen is dan ook erg trots dit boek te mogen tonen.
Het Van Bronckhorst-Batenburg Getijdenboek is een klein boek, circa 12 bij 8 centimeter. Bijzonder is dat het boek 7 pagina vullende miniaturen bevat. Eén daarvan is tot en met de kerstvakantie te zien in de tentoonstelling Wijvenwereld. In het getijdenboek bevindt zich een afbeelding van een rijk geklede dame, knielend op een bidstoel. Het is waarschijnlijk Catharina van Gronsveld. Ze kreeg het boek van haar man, Dirk II van Bronckhorst-Batenburg. www.museumwijchen.nl
Een eigenzinnig museum waar moderne tentoonstellingen met focus op moderne kunst en de streek samenkomen in wisselende tentoonstellingen gecombineerd met permanente tentoonstellingen over wonen, leven en werken.


De tentoonstelling over Ru Paré is nu te zien. Ru Paré is een kunstenares die in Druten werd geboren. In de Tweede Wereldoorlog heeft zij de schilderskwast neergelegd en ging in het verzet. Zij heeft kans gezien om 52 Joodse kinderen het leven te redden door ze aan onderduikadressen te helpen door heel Nederland. Het Museon in Den Haag heeft hier enige jaren geleden een tentoonstelling over gemaakt. • Bezoek museum Tweestromenland ook voor de permanente tentoonstellingen. Verbaas je over de de Prehistorie en de Romeinse tijd en bewonder de werken van Jac Maris. www.museumtweestromenland.nl
Sfeer in huis, lekker aan het genieten, bezoek dan eens de websites van kunstenaars uit het Land van Maas & Waal. De streek kent wereldberoemde kunstenaars zoals Ronald Tolman, Huub en Adelheid Kortekaas, Harrie Gerritz, Ad Arma , Kieta Nuij en Kenne Gregoire. Ontdek ze vanuit je luie stoel en ga op pad. Voel je welkom in een regio, waar je ook veel kunst tegenkomt op staat.
Heb je zin om zelf aan de slag te gaan? Bezoek dan Atelier Toonbeelden en de website. Toon van Gelder, biedt samen met partner Alette jou, je familie, vrienden of collega’s een workshop op maat. Altijd welkom voor een vrijblijvend bezoek. www.toonbeelden.nl

Onze



Meubelspuiterij
Meubelspuiterij Maas & Waal
Energieweg 19 Beneden-Leeuwen
Tel. 0487-593001 / 06-13444237 www.meubelspuiterijmaasenwaal.nl




Meubelspuiterij Maas & Waal
Energieweg 19 Beneden-Leeuwen Tel. 0487-593001 / 06-13444237 www.meubelspuiterijmaasenwaal.nl

Energieweg 19 Beneden-Leeuwen Tel. 0487-593001 / 06-13444237 www.meubelspuiterijmaasenwaal.nl

STAM TECHNIEK AEROCLEANING


Energieweg 19b Beneden-Leeuwen Tel. 06-57487757 www.stamtechniek.nl
AEROCLEANING


Energieweg 19b Beneden-Leeuwen Tel. 06-57487757 www.stamtechniek.nl
Energieweg 19b Beneden-Leeuwen Tel. 06-57487757 www.stamtechniek.nl
Rolluiken zijn een multifunctioneel product. Met rolluiken voor je ramen kun jij niet alleen uitslapen, maar het zorgt er ook voor dat jouw woning beter geïsoleerd is. Dit houdt in dat de warme lucht in de zomer minder de kans krijgt de woning binnen te dringen en je woning koel blijft. Dit geldt ook voor de koude lucht in de winter. Daarnaast hebben rolluiken een geluidswerende en inbraakwerende eigenschap.




Met meer dan tien verschillende zonweringen voor binnen en buiten vind je altijd een geschikte oplossing voor jouw wens. Vraag ons om advies!
Op zoek naar een andere daglicht oplossing? Dan ben je bij ADVIBA aan het juiste adres.











Deze trend is niet gloednieuw, maar zeker een keeper! En wat zijn wij er gek op: accessoires in bijzondere vormen, meubels met rake rondingen en fauteuils zo bollig als een wolkje. Laat je verwonderen door curvy vormen zoals: tonvormig, kiezelvormig en kegelvormig. Maar ook vrije vormen afgeleid uit de natuur.


Deze vormen komen veelal zacht over, om dat te benadrukken zien we veel gladde, gemêleerde en zachte materialen.
In deze trend spotten we eigenlijk alle kleuren, want het leuke is dat het voorál draait om de vormen.

Het draait om ronde vormen

Deze wintereditie aandacht voor heel anders wonen. Wonen in een ander land. Op veel plekken in Nederland worden Oekraïners op gevangen. Het is oorlog in Oekraïne. Veel mensen hebben hun land ontvlucht. We laten hen niet in de kou staan. Ook het Land van Maas & Waal draagt haar steentje bij.
In de gemeente Beuningen is een noodopvang ingericht op het Asdonck terrein. Tegenover de RK kerk staan 41 chalet woningen, waarin tussen 220 en 240 personen kunnen worden opgevangen. Het terrein is door de gemeente ingericht met algemene voorzieningen, parkeerplaatsen en groenstroken. Vele vrijwilligers zijn ook betrokken bij deze opvang.




Samenwerking met vele vrijwilligers.

Oekraïense vluchtelingen kunnen zich op deze locatie laten inschrijven in de Basisregistratie personen. Ze kunnen hierdoor aanspraak maken op leefgeld, school, werk en inkomen.



Deze noodopvanglocatie is er voor maximaal 5 jaar. Als de noodopvang voor Oekraïners binnen de periode van maximaal 5 jaar niet meer nodig is, bekijkt de gemeente dan of an-
dere groepen (vluchtelingen uit andere landen, mensen die met spoed op zoek zijn naar een woning of reguliere woningzoekers) gebruik kunnen maken van deze locatie.
De gemeente is verantwoordelijk voor veel zaken zoals het inrichten van de locaties: van keuken en douche tot aan meubilair en gebruiksartikelen. Maar ook bijvoorbeeld voor de zorg, niet alleen voor fysieke problemen maar ook psychosociale zorg. En voor het onderwijs aan de kinderen. Er is gezorgd voor een dagelijks aanspreekpunt ter plekke en ook andere zaken, zoals beveiliging op de locatie, coördinatie van alle hulp en meer. Dit alles gebeurt ook in samenwerking met vele vrijwilligers.
Binnenkort komen er verlichte kerstbomen bij ieder chalet, want met elkaar willen we de Oekraïners een warm gevoel geven in deze voor hen verdrietige tijd.



Asdonck terrein

Patiënten uit heel Nederland komen naar het Flebologisch Centrum Grave om spataderen en aambeien te laten behandelen. De specialisten van FCG maken gebruik van de modernste en nieuwste behandeltechnieken.

De kliniek kent korte wachttijden en heeft sinds 2010 het kwaliteitskeurmerk (www.ZKN.nl). Bovendien vergoeden zorgverzekeraars het overgrote deel van de behandelingen. Bezoek de website voor meer informatie: www.spataderen-fcg.nl of neem vrijblijvend telefonisch contact met ons op: 0486-420096


Klinkerstraat 8-10 5361 GW Grave Tel: 0486 - 42 00 96 info@spataderen-fcg.nl




Bezoek de website voor meer informatie: www.spataderen-fcg.nl

Het land van Maas en Waal is trots op zijn streekproducten. Dit verhaal gaat over de periode 1900 – 1950. Er ontstaan zuivelfabriekjes en enkele coöperaties. Het land van Maas en Waal en het westelijk deel van het Rijk van Nijmegen kennen in de vorige eeuw geen grootschalige veeteelt. De melk is bestemd voor eigen gebruik en als ruilmiddel. Door de verstedelijking ontstaat steeds meer vraag naar melk en melkproducten. De behoefte aan op de verkoop gerichte productie wordt geboren. Samenwerking ontstaat.

Op den duur komt er bijna in ieder dorp wel een zuivelfabriek en zelfs in veel buurtschappen verschijnen ze. In het hele gebied tussen de Maas en de Waal staan er op den duur liefst 33 zuivelfabriekjes. De meesten ervan zijn opgericht tussen 1910 en 1925. De oudste zuivelfabriek in dit gebied is de Coöperatieve Zuivelfabriek 'De Hoop' in Beneden-Leeuwen. Hij dateert uit 1895.
Het doel van de meeste fabrieken is vooral het maken van boter. Daarnaast leveren de fabrieken vaak ook
andere producten zoals volle melk, karnemelk, en taptemelk waar bij het boter maken het vet al uitgehaald is. Een belangrijke taak van de fabrieken is ook de verkoop van de producten. Een grote afnemer is de Botermijn in Den Bosch.
Van handkracht naar stoomkracht
Bij de oprichting zijn het bijna allemaal handkrachtfabrieken. Ze beschikken over een centrifuge die met de hand wordt aangedreven. In een enkel geval is sprake van een benzinemotor voor de aandrijving van de centrifuge zoals in Altforst. Later gaan veel fabrieken over op stoomkracht.
Om de fabrieken rendabel te houden zijn grote investeringen nodig. Kleine fabriekjes kunnen de investeringen niet opbrengen. Bij de schaalvergroting speelt ook de melkprijs een belangrijke rol: grotere melkfabrieken kunnen betere prijzen bedingen. Er verdwijnen steeds meer zelfstandige fabrieken. Na de Tweede Wereldoorlog zijn er nog maar zes over in het Land tussen Maas en Waal. Veel kleinere fabrieken uit het Rijk van Nijmegen gaan op in de Coöperatieve Melkinrichting 'Melkerij Lent' in Nijmegen. Bron: www.hetverhaaltussenmaasenwaal.nl









 Shop LVMW met medewerking van Bij NETT Wonen Druten, Bij NETT Kado Druten, JM Juweliers Beneden-Leeuwen, Beuningen en Druten, De Zaak van Ruud Beuningen en Woonboulevard Wijchen
Shop LVMW met medewerking van Bij NETT Wonen Druten, Bij NETT Kado Druten, JM Juweliers Beneden-Leeuwen, Beuningen en Druten, De Zaak van Ruud Beuningen en Woonboulevard Wijchen






De Vierjaargetijden Beuningen, Chocolaterie Tweeling Beneden Leeuwen, Schoenmode Verploegen Wijchen,























































































Wil jij jezelf elke dag stralend voelen, dan ben je bij Wendy van de Geer en haar team aan het juiste adres. Damesmodezaak Beau Vous, gevestigd in het Hart van Beuningen op het Julianaplein, combineert fashion, gevoel voor styling met gastvrijheid.


Een eigentijdse collectie wordt aangeboden met merken als o.a. Esqualo Poools, Rosner, MAC, Rino & Pelle, Cream, Isay en Qui. En hier wordt het mooie Nederlandse merk NUKUS binnenkort aan toegevoegd.
Voor elk moment van de dag en/of gelegenheid is Beau Vous het juiste adres voor de moderne vrouw, die goed in haar vel wil zitten 24/7.
Beau Vous Julianaplein 22, Beuningen Volg ons op Facebook en Instagram

Wendy “ Ik ben trots op Beau Vous. De winkel voelt voor mij persoonlijk als een warme jas. Dat gevoel geef ik graag door aan iedere klant. Bekijk hier onze kerst fotoshoot, die we met het team hebben gemaakt op de sfeervolle kerstshow bij Tuincentrum Bull. Ik nodig je graag uit in onze winkel. Welkom.”
 Wendy van de Geer
Wendy van de Geer
















Bewegen in een warmtecabine, ontspannen in de ozoncabine en de juiste voedingsbegeleiding en mindset. Dat is wat Zlim jou kan bieden. Bij Zlim is elke klant uniek en volgt een individueel programma. Bovendien bereik je meer dan alleen een slanker lichaam. Door te zlimmen ben je fitter en gezonder en je voelt je ook weer zelfverzekerd en gelukkig.


Waar sta je en wat wil je bereiken? Tijdens een intake, bespreken we jouw persoonlijke doelen en volgt een uitgekiend behandelplan, speciaal voor jou samengesteld door onze gediplomeerde diëtistes en leefstijlcoaches op basis van je intake, gewicht, leeftijd, conditie en algemene gezondheid. Bewegen in combinatie met individuele voedings,- en leefstijlbegeleiding, zorgt ervoor dat je lekker in je vel zit en een gezonde levensstijl ontwikkelt.
GEÏNTERESSEERD?



Plan nu een afspraak in en ontvang 2 gratis proeflessen!
Actie geldig tot 1 februari 2023



De Zlim methode is gebaseerd op gezond eten in combinatie met doelgericht bewegen en ozontherapie. Sporten bij Zlim, in een warmte-cabine van 36 graden, is kort en effectief. Onze coaches zorgen ervoor dat je in een work-out van een half uur het maximale resultaat behaalt. In een verwarmde cabine voer je onder deskundige begeleiding bewegingen uit. De oefeningen worden liggend uitgevoerd, zodat je rug en gewrichten worden ontlast.


Bij Zlim Beuningen hebben wij een Zelfcare afdeling, waar verschillende verwen-, ontspanningsen verbeterbehandelingen worden uitgevoerd. De behandelingen zijn:
bron foto’s: Heerlijkheid Leur en Bezoekerscentrum Land van Heerlijkheden




Na het bewegen in de warmtecabine sluit je af met ozontherapie. Gedurende 15 minuten onderga je een ontspannende huidbehandeling in de ozoncabine, die voorzien wordt van ozonzuurstof. Ozon zorgt ervoor dat de poriën van je huid worden geopend. De ozonzuurstof stimuleert de bloeddoorstroming en de verwerking van afvalstoffen.

Zlim gaat met de tijd mee!
Per 1 januari 2023 werkt Zlim Beuningen met een super app met veel verschillende functies. Afspraken in plannen was nog nooit zo makkelijk. Met de app word je sport journey bijgehouden, doormiddel van grafieken kun je je eigen progressie zien. Daarnaast wordt je online op de hoogte gehouden van de nieuwste acties, wekelijkse recepten en zlim nieuws.















Geen zin in alcohol. Maak een heerlijk alcohol vrije cocktail. Bijvoorbeeld met een alcohol vrije gin of meng ginger ale met munt en gember voor een beetje pit.


Heerlijk als aperitief: onze eigen Restaurant Old Skool Gin Tonic.
Kloovenburg, Gatekeeper, Zuid-Afrika, 2021 Een heerlijke volle witte wijn. Rijpt op rvs. De wijn toont honingachtige tonen van tropisch fruit, ananas en groene appelschil. Lekker bij bijvooreeld vis hoofdgerechten. Maar ook een perfecte wijn bij een vlees voorgerecht. Zoals tartaar of carpaccio, waar een frisse touch aan toegevoegd is.

en Ceviche Bisschofliche Weinguter, riesling, Moesel, Duitsland. Mijn favoriete wijn om mee te beginnen. Een glas riesling. Geen klassieke zoete wijn maar een mooie strak droge riesling, groene tonen en ziltigheid in de afdronk. Dus een heerlijke begeleiding bij rauwe vis gerechten. Zoals sashimi, ceviche of sushi.


Wijnskool, Shiraz, Zuid-Afrika, 2019
Wat is nou lekkerder dan een Shiraz in de winter? Mooi vol krachtig en niet teveel tannine. Lekker bij gerechtjes met een iets oosters tintje. Zoals deze beef Rendang.
Als heerlijker afsluiter een kaasplank.
Rode Port kan natuurlijk altijd. Maar denk ook eens aan een glas witte Port van 10 Jaar oud. Mooi hout gelagerd en nootachtige tonen, maar ook een glas sherry is heerlijk zoals de Pedro Ximinez.

biedt veel entertainment, activiteiten en natuurlijk de curlingcompetitie. De finale hiervan vindt plaats op 5 januari.
Van 17 december t/m 18 januari
Beuningen On Ice viert de 10de editie en biedt schaatsplezier en gezelligheid voor jong en oud op de grootste ijsbaan in de regio van maar liefst 1000m2 ijsbaan en 300 m2 kinderijsbaan.

Drie weken lang is er op de Ooigraaf in Beuningen elke dag wat te beleven. Een bruisend programma
Op zaterdag 17 december barst het ijsfeest los met livemuziek van Slamm.
Samen de Winter Vieren: Voel je welkom en de toegang is gratis.
De schoolschaatsweek start op maandag 19 december en op dinsdagmiddag 20 december is er weer een gezellige seniorenmiddag.
Het is hier elke dag volop genieten. Ontmoet elkaar in het gezellige
Winterwonderland van zaterdag 16 december tot en met zondag 8 januari
In het gezellige centrum van Wijchen vind je op de markt de ijsbaan, waar je voor, tijdens en na het shoppen geniet van een winters tafereel. Trek aan die schaatsen of geniet in het schaats café . Wijchen biedt de kinderen weer een uitgebreid schoolschaatsprogramma en

hou jij van curling, dan ben je hier ook aan het goede adres. Er zijn tevens een aantal avonden gepland met entertainment. Dus pak die agenda en blok jouw middagje of avondje uit.
Op 17 en 18 december is het helemaal genieten als er in het centrum het Sprookjesfestijn plaatsvindt. Gratis entree voor iedereen. Je waant je in een winters sprookje,
en ruime ijs café.
Deze editie wordt weer mogelijk gemaakt door ruim 300 vrijwilligers, waaronder ijsmeesters, kassa, catering – en barmedewerkers. Ook kun je schaatsen hier huren, Dus lekker samen de ijsbaan op of vier je kinderfeestje op een heuse ijsbaan!
Volg Beuningen On Ice op Facebook en bezoek www.beuningenonice.nl
dus weer volop genieten voor jong en oud.
Meer informatie www.wijchenschaatst.nl
Schaatplezier van 10 december tot en met 7 januari!

Voor de eerste keer vindt in Druten er een ijsfestijn plaats, die direct opent in het weekend van Dickens Druten. Op 10 december is de openingsavond en op 11 december ervaar je de wereld van Charles Dickens in heel Druten en zeker in Winter Village Druten.



De overdekte ijsbaan van 16 bij 24 meter is van ‘echt ijs’. Voor de kleinsten die voor het eerst op de ijzers treden en voor de ervaren schaatsers. Op de schaatsbaan worden verschillende activiteiten georga-
niseerd en in de aprés ski tent is het gezellig ontmoeten en plezier hebben ,want er is een uitgebreid entertainment programma.
Er wordt samengewerkt met vele verenigingen uit de gemeente Druten en ook is er op 15 december een modeshow door de detaillisten uit Druten.
Ook is er een heuse fluitketelschuiven competitie. Kom langs en geniet mee.
Op 27 december is de finale.
Wie elke dag actief bezig wil zijn, zijn schaatsen nu wel of niet onderbindt, maar zeker van skaten houdt, kan in en rond Wijchen een mooie route van 32,3 kilometer afleggen. De route wordt aanbevolen op de site schaatsen.nl, veilig genoemd en beoordeeld met 5 sterren.
• Je kunt de route beginnen bij het Europaplein aan de Meester van Coothlaan.
• Vanaf de bushalte skeeler je het centrum van Wijchen uit via de Balgoijseweg.
• Voor de Vormerse Plas ga je linksaf de Ravensteinseweg op en skeeler je richting de rivier de Maas.
• Je skeelert hier een heel stuk langs tot aan Batenburg.
De organisatie staat voor samenwerking, schaatsplezier, ontmoeten en heeft een duurzame aanpak met een recycle en cashcard beleid.
Bezoek voor informatie over openingstijden, entertainment programma, schoolschaatsen, kinderfeestjes, vrijschaatsen en tickets www.wintervillagedruten.nl/ programma.

• Hier ga je met de voetveer de Maas over en rij je helemaal terug langs de andere kant van de rivier.
• Vervolgens skeeler je via de Oude Maasdijk richting de Graafseweg en steek je de Maas weer over.
• Via het fietspad kom je door Lunen en ga je weer richting Wijchen. Het percentage asfalt van de route is 100 procent.


3 jaar geleden is deze Bed & Wellness geopend en recentelijk overgenomen, waarbij er vele nieuwe faciliteiten zijn toegevoegd. “Met deze Bed & Wellness willen we mensen een unieke belevenis geven waar privacy, kwaliteit, luxe en genieten centraal staan.

Dit uit zich in de 2 privéruimtes die beide zijn uitgerust met vele faciliteiten. Ook kan er in beide ruimtes overnacht worden, om je wellness-ervaring nog verder uit te breiden.
In de ochtend serveren we een heerlijk ontbijt voor de gasten, met verse broodjes en ook mogelijk uit te breiden met champagne. In de wellness hebben onze gasten de mogelijk-


heid om volledig privé te dineren of te genieten van een lunch, met gerechten die besteld kunnen worden van de kaart.
Maar dat is nog niet alles. Onze gasten vinden het heerlijk om nergens heen te hoeven gaan en alle faciliteiten bij de hand te hebben. Om die reden verzorgen we ook een private dinner en denken we mee met bijzondere gelegenheden.

Vaak wordt een bezoek aan onze wellness als verrassing geboekt en willen zij hun partner verrassen. We brengen de wellness dan volledig in romantische sferen, inclusief verse rozen, ballonnen en een flesje bubbels.




Verjaardagen, huwelijksaanzoeken, vriendinnenmiddag en een babymoon, we hebben het allemaal al voorbij zien komen en denken dan graag mee met de wensen van onze gasten.
Hoe fijn is het om volledig te kunnen ontsnappen aan de dagelijkse drukte en je even in een compleet andere wereld te banen. Wij nemen de tijd voor je. Voor vragen of reserveringen kun je terecht op onze website, maar je mag ook altijd telefonisch contact met ons opnemen. We denken dan graag met je mee.”

Wie weet, tot snel!

De Maas suite is een heerlijke knusse ruimte met geweldige faciliteiten: een Finse sauna met geïntegreerde infrarood, stoomcabine en een jacuzzi. In het midden van de ruimte een plek om af te koelen onder de regendouche. Naast de openhaard is een zithoek gecreëerd waar je heerlijk kunt genieten.

Ook vind je er een grote 2 persoons loungesofa, waar je samen een filmpje kunt kijken. Ook is het mogelijk te overnachten en je wellness ervaring nog even te verlengen.
Ruim 125m2 aan wellnessruimte is in Nederland bijzonder uniek te noemen.
In deze wellness zijn er vele faciliteiten, zoals een Finse sauna, Full Spectrum infrarood sauna, jacuzzi en een zwemspa, waar je tegen de stroming in kunt zwemmen.


In het midden van de ruimte staat de openhaard met een heerlijke loungehoek om te ontspannen en een zithoek, waar je kunt genieten van je ontbijt, lunch of private dinner.
Op de 2e etage vind je het ruime slaapvertrek met uitzicht op de zwemspa. Welke ook een buitenruite bied voor ontbijt in de zomer of lekker kunt afkoelen.







Het is winter! Dus trek je winterjas en handschoenen aan en trek eropuit in het Land van Maas en Waal. Wandelen door de winterse uiterwaarden, over dijken en door de karakteristieke dorpen. Ook tijdens deze donkere en koudere dagen is er genoeg te ontdekken en te beleven. Schaatsen op het marktplein, een winterse wandeling, of genieten van lekker eten.

Laat je culinair verrassen in het Land van Maas en Waal. Even bijkomen van een mooie wandeling door de natuur, of tijdens een leuke avond uit. Het aanbod aan restaurants is even gevarieerd als het landschap zelf. Van luxe restaurants tot gezellige en sfeervolle bistro’s, in het Land van Maas en Waal is genoeg keuze voor iedereen! Wij hebben wat culinaire hoogstandjes voor je verzameld.

Scan de QR-code voor de lekkerste tips in het Land van Maas en Waal!
Het land van Maas en Waal heeft genoeg te bieden voor jong en oud! Wij hebben de leukste evenementen voor je verzameld.
Scan de QR-code voor de actuele agenda!

Organiseer jij zelf een evenement, maar staat deze nog niet in de agenda? Meld je evenement gratis aan via landvanmaasenwaal.nl/evenement-toevoegen.




GJBART • Persoonlijk en deskundig advies. • Gratis proefplaatsing. • Flexibiliteit in aanschaf en budget. • Goede bereikbaarheid. • Iedere werkdag geopend van 9.00 uur tot 16.00 uur. Andere tijden/dagen op afspraak.




Kunst in grote verscheidenheid, van van schilderij tot beelden en sculpturen.

GJB lijsten is al meer dan 50 jaar fabrikant van hoog waardige, handgemaakte kwaliteitslijsten, in alle formaten en kleuren naar wens. Ook kunnen we alle soorten lijsten restaureren.
Geniet, beleef en raak geïnspireerd op de Onderstal 1 in Beneden Leeuwen, waar GJB Art & Frames hedendaagse kunst aanbiedt van figuratief tot abstract, van groot tot klein, van schilderij tot beelden en sculpturen. Kunst die je kunt kopen, maar ook kunt huren of huren met opbouw van spaartegoed. Bezoek ook de wisselende exposities.



Janine van Welie is eigenaar en vindt, dat kunst voor iedereen toegankelijk moet zijn. “Het doel is kleur en creativiteit in het leven van mensen te brengen. Daarmee kan GJB-art uw woon en werkomgeving verlevendigen en daarmee een omgeving creëren die verbeelding, ontspanning, communicatie en innovatie stimuleert. In onze galerie hebben we kunst die voor iedereen toegankelijk is. Daarnaast kunt u uw eigen kunstwerk bij ons laten inlijsten.”


Onder de galerie is het atelier GJB Lijsten gevestigd, dat al meer dan 50 jaar producent is van exclusieve lijsten. Hier wordt ingelijst voor diverse kunstenaars, lijstenmakers, galerieën en kunsthandels. Ervaar zelf vakmanschap en voel de passie voor kunst, het inlijstwerk en een mooi resultaat. Kom gerust eens kijken en laat je verrassen door de collectie gewoon zonder afspraak.




Je bent van harte welkom!

Janine van Welie
Laat je verrassen door kleur, objecten, kunst & topvakmanschap
"Kunst brengt kleur en creativiteit in het leven."
Toen me werd gevraagd of dat ik vijf tips over Maas & Waal wilde geven moest ik wel even goed nadenken. Want als promotor van gemeente Wijchen kan ik wél heel veel tips bedenken! Maar het is me toch gelukt om het bij vijf tips te houden (al heb ik er toch stiekem wat extra tips erin verwerkt).

Iedereen die voor het eerst in het centrum van Wijchen komt is verbaasd over hoe gezellig het is! Mede door de vele gezellige terrassen op de Markt en in het Horecastraatje, waar in de zomer en de winter gretig gebruik van gemaakt wordt. En de vele leuke winkels, zoals diverse conceptstores die zich in de winkelstraten bevinden. Overigens is Theehuis ‘De Eikenhorst’ in Alverna ook leuk om te bezoeken in de zomer.
Kasteel Wijchen kunnen we natuurlijk niet overslaan in dit rijtje. Een prachtig kasteel uit de 14e eeuw. Niet alleen een plaatje aan de buitenkant, maar zeker nu het helemaal verbouwd is van binnen een bezoekje aan het museum waard! Kasteel Hernen is een middeleeuws kasteel wat ontzettend leuk voor kinderen is door de unieke overdekte weergangen met de ‘pratende’ lantaarn.
Als je even wil afschakelen dan kan dit nergens zo goed als in Leur. Een landgoed dat al sinds 1748 in particulier bezit is. Wandel langs de zwierige landwegen met oude lindebomen en monumentale panden, de weilanden met de Angus koeien en door de bossen met vele paddenstoelen. En vergeet vooral ook niet even langs de prachtige dorpskerk uit de 13e eeuw en het statige Huis te Leur te lopen of te fietsen en te eindigen met een warme kop chocolademelk bij de Leurse Hof.
Batenburg is soort openluchtmuseum en hierdoor mega fotogeniek. Erg leuk voor hobbyfotografen zoals ik. De straten en huizen zijn pittoresk en de kasteelruïne is een pronkstuk van romantiek. En met de voetveer steek je van mei t/m september de Maas over naar Demen, gemeente Brabant.
BioRosanne Pak (40) is vanaf 1 januari 2023 centrummanager van Wijchen centrum. Naast het promoten van het centrum van Wijchen zet ze zich met stichting Wijchen = Promoties in voor de promotie van heel gemeente Wijchen. En ontdekt ze tijdens het wandelen samen met haar partner Bas en hun twee hondjes nog steeds regelmatig bijzondere plekken in haar favoriete gemeente.

De theaterzaal is omgetoverd tot de gezelligste huiskamer van Maas & Waal.
* 28 december TOP2000 CAFE POPQUIZ!
Meld je team aan via info@bogerddruten.nl
De kosten bedragen € 20,- per team.
* 29 december TOP2000 CAFE FEESTAVOND





ToencoronauitbrakgebruikteBenvanOoijen(directeur vanDeTuinenvanAppeltern)zijnFacebookpaginaals dagboekendeeldezijnwekelijkservaringenen overwegingenmeteensteedsgroterwordende lezersgroep.Coronaheeftveelveranderdendoetdatnog steeds.Zijnkijkalsondernemer,vader,dorpsgenooten tuinmanopalleswatgebeurt,wordtzonderbedenkingen, maaraltijdpositiefeindigendweergegeven.Benprikkelt, analyseertenontroertdoorzijnopenen puremaniervan schrijven.Hijverhaaltoverzijnwerk,zijnmedewerkers,zijn gezin,zijnbijzondereontmoetingenendegebeurtenissen inwereldenzijndorp.
In Beuningen is het Lichtjesavond en ben je vanaf 16.00 uur welkom in het gezellige Hart van Beuningen.

Dansen op de beste hits uit de Top2000 mmv DJ’s Edwin Meeuwsen en Ronn Laam. De Top2000 feestavond begint om 20:00 uur, entree is gratis!


Cadeau om te geven/te krijgen
Een verhalenbundel geschreven door Ben van Ooijen, directeur van De Tuinen van Appeltern. Het boek bevat 100 van Ben's mooiste Facebookverhalen. Zijn kijk als ondernemer, vader, dorpsgenoot en tuinman op alles wat gebeurt, wordt zonder bedenkingen, maar altijd positief eindigend weergegeven. De reacties van zijn volgers, lezers en honderden collega-ondernemers hebben geleid tot deze bundel, welke is te bestellen via www.appeltern.nl/nl/bens_nieuwe_boek/ TIP Combineer je cadeau met entreekaartjes voor het volgende tuinseizoen en geniet samen van een prachtige wandeling en volop tuininspiratie.
Elke dag kun je een mooie toer maken door Het Land van Maas & Waal. Bezoek de gezellige centra van Beneden Leeuwen, Druten, Wijchen en Beuningen met sfeervolle zaken met mooi samengestelde collecties of ga lekker je streekproducten inkopen. Op 17 december combineer je dat met sfeervolle events.
In Wijchen gaat het Sprookjesfestijn van start bij het prachtige kasteel in het centrum van Wijchen . Afsluiten tot in de late uurtjes kun je bijvoorbeeld op de gezellige ijsbaan van Beuningen On Ice of Druten met entertainment of combineer je bezoek met een leuke film in de gezellige servicebioscoop in Wijchen.
In Wijchen Centrum kun je voor, tijdens en na het shoppen genieten van een winters tafereel. Trek aan die schaatsen. Meer info www.wijchenis.nl
Bezoek een van de vele carnavalsoptochten in het weekend van 18 en 19 februari!










